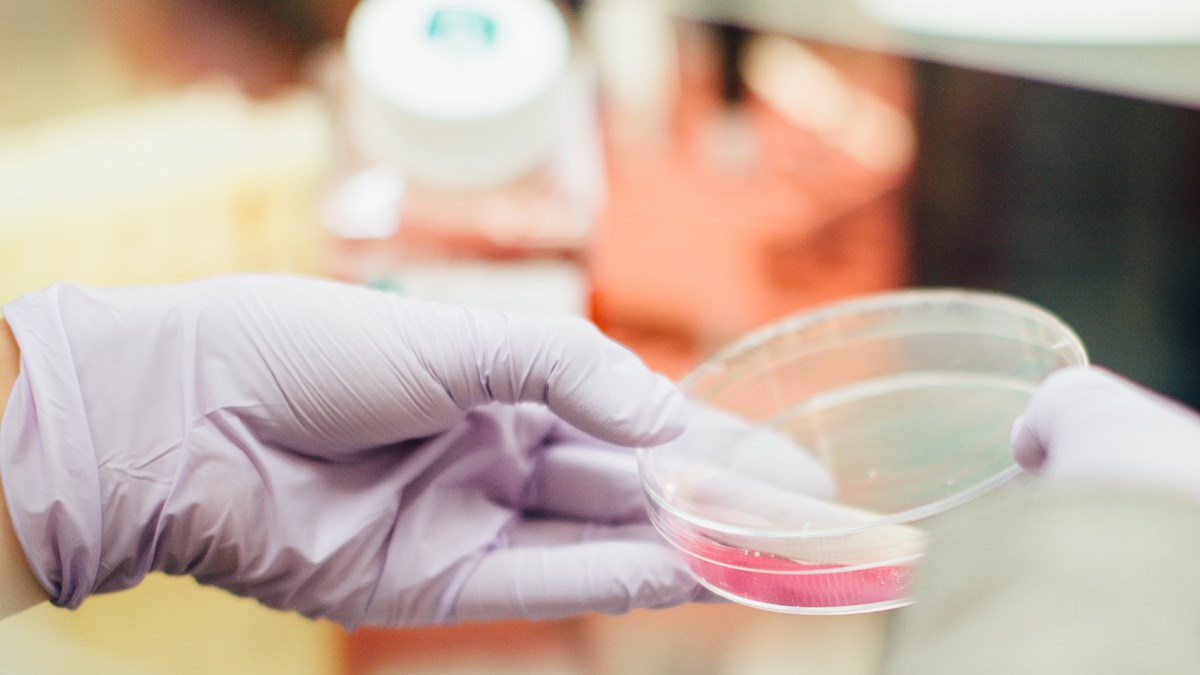

Donate tissue to the Biobank
Donate a sample of your Salivary Gland Cancer tumour. Help drive forward research, and get your own tumour profiled.
For researchers looking for new ways to treat Salivary Gland Cancers, being able to work with patients' tumour samples brings big advantages.
Dr Rob Metcalf is building a national biobank of salivary gland cancer tumour tissue at the Christie Hospital in Manchester.
If you’re undergoing surgery anywhere in the UK to remove a salivary gland tumour, you can choose to donate your tissue to this Biobank. It will be invaluable to Rob and other researchers working on new treatments for these rare diseases.
It will also mean your tumour can be profiled. This reveals unique characteristics of your disease at a molecular level. In turn, this can help doctors understand which treatments are most likely to deliver the best results for you. This is sometimes referred to as targeted therapy or personalised medicine.
If you wish to donate tumour tissue to the biobank, please contact Dr Metcalf’s Clinical Secretary Jennifer Hill in the first instance.
Telephone: 0161 956 1167
Email: [email protected]
Rob Metcalf, Consultant Medical Oncologist on his research into ACC and the Biobank.
My research role
I’m Rob Metcalf, I’m a Consultant Medical Oncologist. I work at the Christie Hospital in Manchester. My job is actually quite unique in that my clinical interest is focusing predominantly on patients with salivary gland cancers, and also my job is structured such that I spend most of my time doing research. So I spend four days a week at the moment purely on research and one day a week is spent seeing patients.
ACC research
The main goal of my research is to improve patient outcomes with Adenoid Cystic Carcinoma. The way in which I do that is to focus on understanding the disease better, and use that understanding to develop new drug therapies.
I’ve broadly got two approaches to studying Adenoid Cystic Carcinoma. The first is to understand the interaction between the tumour and the immune system with a view to developing new therapies that stimulate the immune system to attack the cancer. And the second is understanding the biology, focusing on the genes that have gone wrong in adenoid cystic carcinoma to develop new drug therapies that target those genes that drive the cancer.
Why we need tumour samples for research
So to go about this research, there are different ways. On the one hand you can study what you call models of the disease in a laboratory. That means tumour cells that grow in a dish in a laboratory. But actually, to translate those findings to patient benefit, what you really need is to study these diseases processes in primary patient tumours.
By primary patient tumours, what I mean is, when patients have surgery for their disease, the specimen is stored in the lab where there operation takes place, and unless patients give their consent, for these tumour samples to be studied, that’s where they stay. So what I do is offer my patients the opportunity to be involved in this research by donating their tumour sample. That allows me to study all these same biological processes in what you call primary patient material.
How patients can contribute to the Biobank
I currently see patients from across the UK, and give them the opportunity to be involved in this research, and contribute their samples to the Biobank. I’m happy to see patients from across the UK to build on what we’ve already developed. Patient involvement in the research has been critical to its success so far, and I think will be critical to its ongoing success. So within the UK clinical community, we’re very well set up to spread the message about what research is going on. I think clinicians in the UK do know what’s happening in Manchester. I’d want to encourage patients if they’re really interested in being involved I’d welcome their involvement.
Image credit: Photo by Drew Hays on Unsplash
Image credit: Photo by Drew Hays on Unsplash